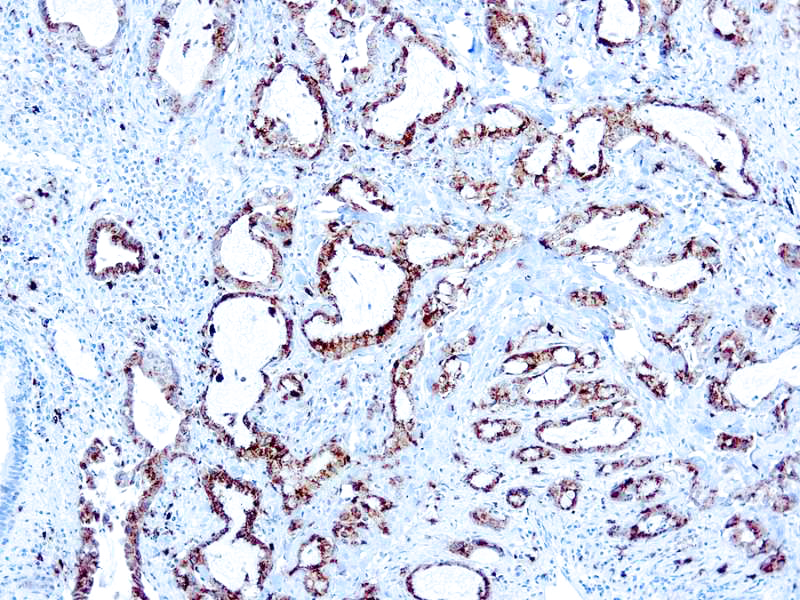

Napsin is found in two isoforms, A and B, with highly homologous gene sequences. Napsin A has a molecular weight of 35.0 kDa and is also known as TA02. Napsin A is an aspartic proteinase which is expressed in the lung and involved in processing surfactant protein B (SP-B). It is also expressed in the kidney. This antibody may be a useful tool as a tumor marker for primary lung adenocarcinoma. Napsin expression correlates with the differentiation grade of lung adenocarcinoma.
Napsin A
SKU: Mob463-
Categories: Primary Antibodies, IVD - For U.S. Market, IVD - Outside U.S. Market
Tags: HL72K-Core Kit, Concentrated, N, Highlighter Product
Description
Additional information
| Catalog No. | Mob463 Concentrated, PDM154 Prediluted |
|---|---|
| Clone | KCG1.1 |
| Isotype | IgG1 |
| Immunogen | BALB/C mice were injected with synthetic peptide from N terminus of human napsin A |
| Species | Mouse |
| Cellular Localization | Cytoplasmic |
| Positive Control Tissue | Lung adenocarcinoma |
| Pretreatment | Citrate Buffer pH 6.0 |
| Incubation & Temperature | 30 min @ RT |
| Intended Use | IVD |
| Detection System | PolyVue Plus – Two Step Detection System or Montage PolyVue Plus Auto Detection System for Montage 360 System |
| Description/Type | Mouse Monoclonal Antibody |
| Format | This product is supplied as a purified immunoglobulin and contains sodium azide as a preservative. |
DATASHEETS & SDS
DATASHEETS & SDS
| Download Datasheet |
| Download SDS Sheet – OSHA |
REFERENCES
REFERENCES
- Chuman etal. FEBS Lett 462: 129, 1999.
- Dejmek etal. Diag Cytoplathol 35: 493, 2007.
- Hirano etal. Lung Cancer 41(2): 155, 2003.
- Ueno etal. Br. J. Cancer 88: 1229, 2003.
Reviews (0)
Only logged in customers who have purchased this product may leave a review.

Reviews
There are no reviews yet.